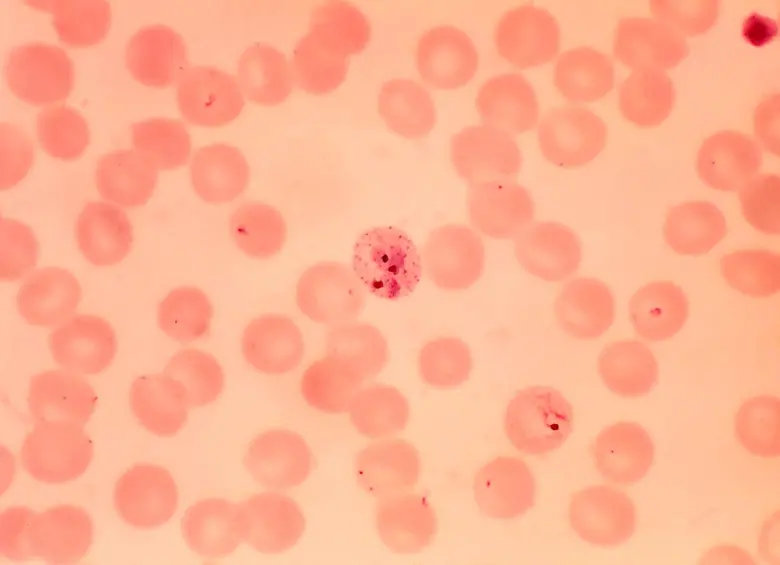
En Medellín diseñaron dispositivo para detectar infección de malaria en 30 segundos

Detectar la infección de malaria, transmitida principalmente por la picadura del mosquito Anopheles, implica un examen en el que una muestra de sangre se observa al microscopio para buscar el parásito o la realización de pruebas rápidas, que funcionan con una gota de sangre y detectan proteínas del parásito en pocos minutos, aunque su precisión es variable.
Son procedimientos rápidas y en teoría fáciles. El problema es cuando aparece el factor geográfico y las dicultades socioeconómicas de un país como Colombia, en donde buena parte de los casos se concentran en zonas rurales y selváticas. Ahí la cosa cambia y el diagnóstico enfrenta retos adicionales: escasez de personal entrenado para leer las láminas, laboratorios distantes o poco equipados, dificultades para transportar las muestras, y pruebas rápidas que pueden fallar cuando la infección es leve. Estas limitaciones retrasan el inicio del tratamiento y dificultan la vigilancia oportuna de los brotes.
Lea: Universidades paisas se sumaron a gigantesco proyecto para combatir la malaria en Colombia con inteligencia artificial
Por ello, el ingeniero electrónico Miguel Ángel Garrido Tamayo, doctor en Ciencias Físicas de la Universidad Nacional de Colombia (UNAL) Sede Medellín, se dio a la tarea de proponer una alternativa prometedora para obtener diagnósticos más rápidos, económicos y asequibles.
En la malaria el parásito actúa como un intruso que reorganiza la “casa celular”, digiere la hemoglobina (proteína que le otorga el color rojo a la sangre) y produce desechos como la hemozoína o pigmento de la malaria, observable solo al microscopio dentro de los glóbulos rojos infectados, en los que aparece como pequeños cristales oscuros.
“Dicho proceso altera significativamente la composición química interna del glóbulo rojo y libera o modifica moléculas naturalmente fluorescentes, como el triptófano. Debido a estos cambios, al iluminar la célula infectada con luz ultravioleta adecuada, esta genera un resplandor marcadamente más intenso que el de una célula sana”, explica Garrido.
También le puede interesar: Investigadores en Medellín desarrollan nanofluidos para combatir el cáncer
Con estos hallazgos, y en colaboración con el Grupo Malaria de la Universidad de Antioquia, el investigador desarrolló el diseño conceptual y electrónico de un espectrofluorímetro portátil, un equipo pensado exclusivamente para detectar malaria en cuestión de segundos y sin requerir conocimientos técnicos avanzados, es decir que cualquier persona podría operarlo.
El dispositov representa un avance especialmente relevante frente a una enfermedad que solo en 2022 registró 249 millones de casos y 608.000 muertes en 85 países endémicos, según la Organización Mundial de la Salud, una carga que ha venido aumentando de forma sostenida en la última década.
Aunque África concentra el 93,6 % de los casos, Colombia mantiene una transmisión activa, especialmente en la costa Pacífica, la Amazonia, Urabá y la Orinoquia. En el país, entre el 60 y 65 % de los casos son causados por P. vivax y el resto por P. falciparum, la especie más peligrosa. Esta última es responsable de la mayoría de las complicaciones graves, que pueden incluir insuficiencia renal o hepática, edema pulmonar o afectaciones cerebrales.
¿Cómo se descifra con luces la malaria en las células?
Según el experto, para la investigación se obtuvieron dos tipos de muestras: glóbulos rojos sanos y glóbulos rojos infectados con P. falciparum. Para descubrir con qué tipo de luz se distinguían mejor, el doctor Garrido utilizó Varioskan Lux, un equipo de alta precisión cuya lámpara de xenón —un tipo de luz muy estable e intensa que permite seleccionar longitudes de onda con enorme exactitud— le permitió ajustar la iluminación según las necesidades del experimento. Con este aparato iluminó las muestras con 76 tipos de luz distintos, desde el ultravioleta profundo hasta el rojo, y así registró el espectro completo de fluorescencia emitida por las células.
Los resultados se plasmaron en dos mapas, uno para células sanas y otro para infectadas, los cuales mostraban cómo reaccionaba cada grupo ante cada tipo de iluminación.
Como a simple vista los mapas eran demasiado complejos, el investigador aplicó “análisis de componentes principales”, esta es una herramienta estadística que ayuda a encontrar los patrones más importantes dentro de grandes cantidades de datos. Gracias a ella determinó que el rango de luz que mejor diferenciaba a las células infectadas se encontraba entre 315 y 335 nanómetros.
En ese intervalo, las células infectadas llegaron a emitir hasta un 234 % más luz que las sanas. El método alcanzó además una precisión del 92 % para clasificar correctamente las muestras durante la fase experimental.
Garrido procedió con el siguiente paso: diseñar un espectrofluorímetro portátil. “La idea es que sea un dispositivo asequible que pueda funcionar como herramienta de tamizaje inicial. Fabricarlo en Colombia costaría alrededor de 2 o 3 millones de pesos frente a los 35 millones que puede costar un espectrómetro convencional”, destaca.
La reducción en costos sería posible gracias al uso de componentes económicos, como led ultravioletas para “excitar” la muestra —es decir, iluminarla con la luz específica que hace que los glóbulos infectados brillen más—, y led sensibles al ultravioleta y al violeta-azul para “detectar” esa luz emitida, como si fueran pequeños sensores que capturan el resplandor generado.
En síntesis, el prototipo funciona de la siguiente manera: tras un lavado simple de la sangre, es decir, una separación rápida en la que se retira el plasma y se aíslan los glóbulos rojos, se deposita una gota en el dispositivo. El equipo ilumina la muestra con un led ultravioleta, mide el brillo que produce, y con base en una ecuación preprogramada determina si la muestra está infectada o no. Todo el proceso toma apenas unos segundos y no requiere conocimientos técnicos avanzados.
Los glóbulos rojos infectados con malaria producen mayor fluorescencia que los glóbulos sanos. Foto: archivo Unimedios.
“El equipo tendría conectividad Bluetooth o wifi para enviar los resultados a una aplicación móvil, la cual registraría los datos del paciente y podría subirlos a un servidor en la nube para su seguimiento global”, añadió el investigador.
Aunque el avance es considerable, el doctor Garrido advierte que todavía falta adaptar la técnica para que funcione directamente con sangre total, sin el lavado previo, lo cual simplificaría el proceso y lo haría más práctico en zonas con recursos limitados. Por ahora, el trabajo de Garrido es un gran avance resultante de la unión entre la biofísica y la parasitología para descifrar el lenguaje luminoso de las células infectadas. Es un hallazgo que no solo ayuda a comprender mejor la malaria, sino que además abren la puerta a un futuro en el que el diagnóstico sea rápido, económico y portátil, especialmente en regiones alejadas de los centros urbanos

Regístrate al newsletter
Regístrate al newsletter